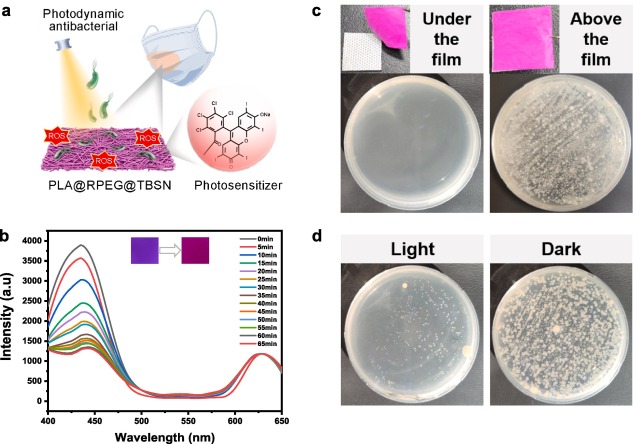

近日,材料科学与工程学部先端材料创新团队在《Chemical Engineering Journal》(中科院一区,TOP期刊,IF=15 91香蕉视频,1)上,发表了柔性多功能H2O2气体传感材料方面的研究成果“Portable multifunctional sensing platform for ratiometric H2O2 detection and photodynamic anti-bacteria using an AIE-featured electrospinning film”。齐鲁工业大学(山东省科学院)材料学部2021级研究生安晓帆为文章的第一作者,高萌副研究员和陶圆圆助理研究员为文章的通讯作者。。

过氧化氢(H2O2)作为一种强氧化性化学物质广泛应用于各种食品加工,水处理,生物医学,临床诊断等环境场景,因此建立便捷灵敏的H2O2蒸气检测方法在安全监控和健康识别等领域具有重要应用价值,柔性荧光传感器由于其操作简单,无损,高灵敏,便携性等的优点,已经成为环境和健康实时气体检测的强大工具,然而,随着柔性传感器在不同领域的广泛应用,除了传感性能的提高,细菌在柔性薄膜表面的污染,可能导致感染风险和随之而来的健康安全问题,因此,开发具有抗菌活性的便携式灵敏气体检测传感器 91香蕉,对保护人类健康和环境安全具有重要意义。
团队利用具有聚集诱导发光(AIE)性能的介孔二氧化硅荧光纳米探针(TBSN)结合孟加拉玫瑰红修饰的聚乙二醇(RPEG)通过静电纺丝技术,制备出具有H2O2传感以及光动力抗菌性能的聚乳酸/聚乙二醇/二氧化硅纳米粒子杂化膜(PLA@RPEG@TBSN),基于比率的荧光变化,柔性PLA@RPEG@TBSN传感器实现了对H2O2蒸汽的高精度,高灵敏度以及实时可视化的检测(图1),其检测限低至7 ppb,此外由于含光敏剂聚合物的掺入,PLA@RPEG@TBSN表现出优异的光动力抗菌活性 91黄,用于口罩上可以在保持有效气体H2O2传感的同时,充分拦截和杀死空气中传播的细菌气溶胶,实现抗菌-传感一体化作用(图2),这一设计策略在开发高效稳定的智能气体传感器和可穿戴设备,特别是与气体传感和健康保护相关的应用中具有巨大的前景。

图1 91视频下载. 电纺PLA@RPEG@TBSN薄膜的制备过程以及传感、抗菌示意图.
图2 91看片. PLA@RPEG@TBSN薄膜在口罩上的抗菌、传感多功能应用.
论文链接:https://doi. org/10. 1016/j 91入口. cej. 2024. 150675 .







